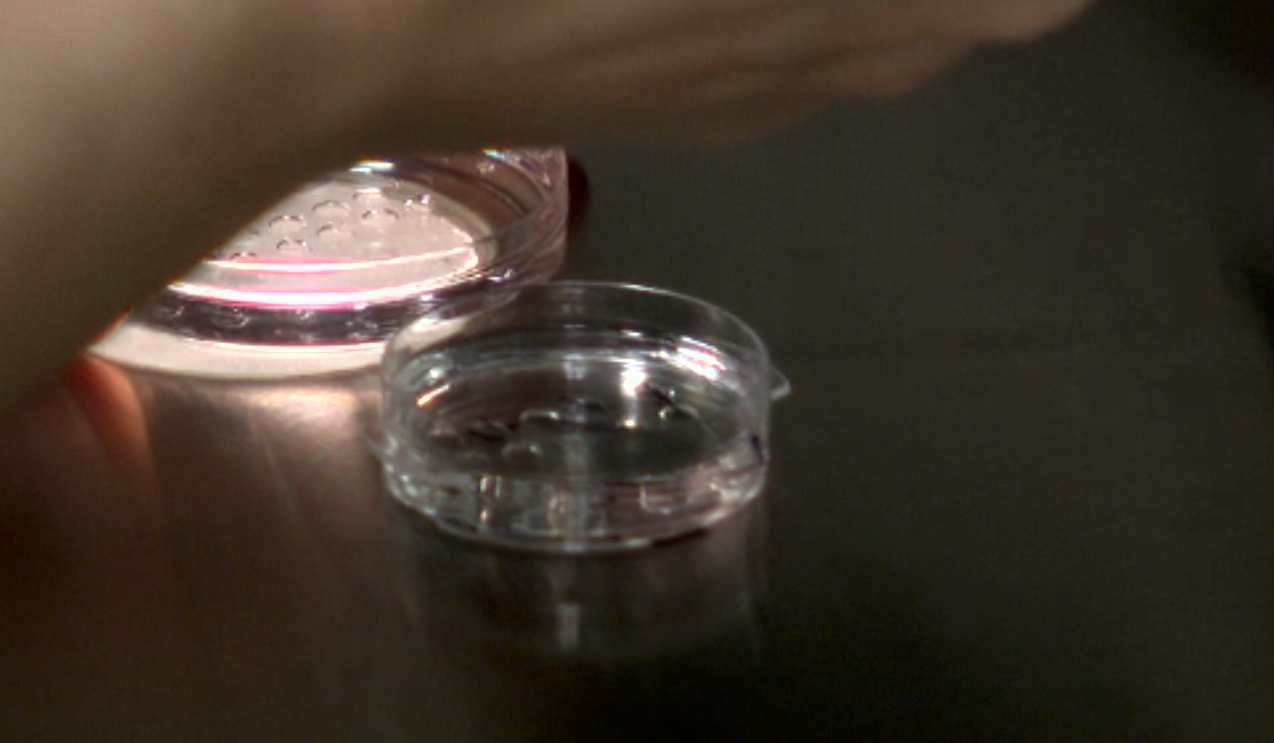
Statul plătește din 2024 câte 3.000 de euro pentru fertilizare in vitro. Diferența o suportă familiile

Un cuplu va da în judecată o clinică de fertilizare in vitro după ce au născut copilul altcuiva: „Au ajuns să-l iubească”
Un cuplu din Florida va da în judecată o clinică de fertilizare după ce a dat naștere copilului altcuiva, pe care, ...
Citeste mai mult ›
Citeste mai mult ›